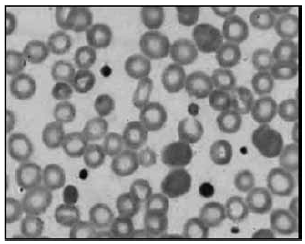
Enunciado 2263472-1

Paciente idoso tem o diagnóstico de Púrpura Trombocitopênica Idiopática, e seu último hemograma revelou valor de 35 000 plaquetas acompanhado de elevação de volume plaquetário médio (VPM) 13.0 !$ \mu !$m3, conforme demonstra imagem a seguir.
Imagem: Lâmina de sangue periférico
(Imagem gentilmente cedida pelo Laboratório de Análises Clínicas da FMABC)
Essa alteração do índice VPM é indicativo do processo patológico de